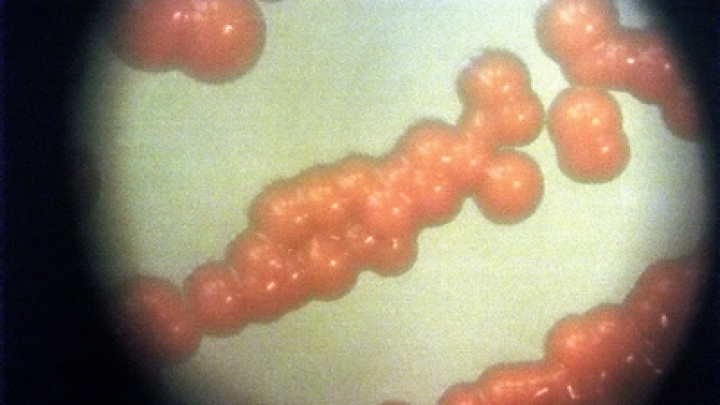

Ученые нашли ключевой белок для «выключения» паразита в мозге человека
Открытие свойств одного из специализированных белков может стать ключом к разработке новых методов лечения.
Международная команда ученых заявила об обнаружении главного «выключателя» паразита Toxoplasma gondii, который есть практически у трети человечества, пишет RuTab.net.
При нормальной работе иммунной системы этот паразит годами остается неактивным, однако при иммунодефиците представляет смертельную угрозу, а у беременных может стать причиной тяжелейших нарушений развития плода. Современная терапия позволяет бороться лишь с острым течением инфекции, не уничтожая спящую форму, локализующуюся в мозге.
Исследователи под руководством Раджаекара Гаджи сосредоточили усилия на транскрипционных факторах — специализированных белках, управляющих экспрессией генов паразита. В ходе работы ученые выделили TgAP2X-7, который оказался критически необходим для жизнедеятельности Toxoplasma gondii. Было отмечено, что после блокировки этого белка химическим веществом, развитие паразита полностью прекращалось, что приводило к его гибели.
Гаджи отметил, что такой эффект был неожиданным, так как паразиты прекращали рост и не могли выжить, что указывает на исключительную важность TgAP2X-7 для их существования. Значимым выводом стало также то, что данный белок не имеет аналогов в человеческих клетках, что позволяет рассматривать его в качестве идеальной терапевтической мишени без риска токсичности для пациента.
Эксперимент также позволил идентифицировать группу белков-киназ семейства TKL, в которой шесть из восьми могут быть незаменимыми для роста паразита. Это открывает целый спектр новых потенциальных лекарственных целей не только для терапии токсоплазмоза, но и для борьбы с болезнями, вызванными родственными паразитами, например, малярией.
Специалисты подчеркивают, что новое открытие служит фундаментом для создания препаратов против хронических форм токсоплазмоза, от которых в настоящее время эффективного лечения не существует. Эксперты уверены, что в условиях растущей устойчивости микроорганизмов к стандартным антибиотикам разработка точечных препаратов против «выключателей» паразита становится особенно актуальной.
Уважаемые читатели «Царьграда»!
Присоединяйтесь к нам в соцсетях ВКонтакте, Одноклассники, Telegram.
Подписывайтесь на наш канал в Дзене. Там все самое интересное.
Если вам есть чем поделиться с нами, присылайте свои наблюдения, вопросы, новости на электронную почту kuzbas@tsargrad.tv